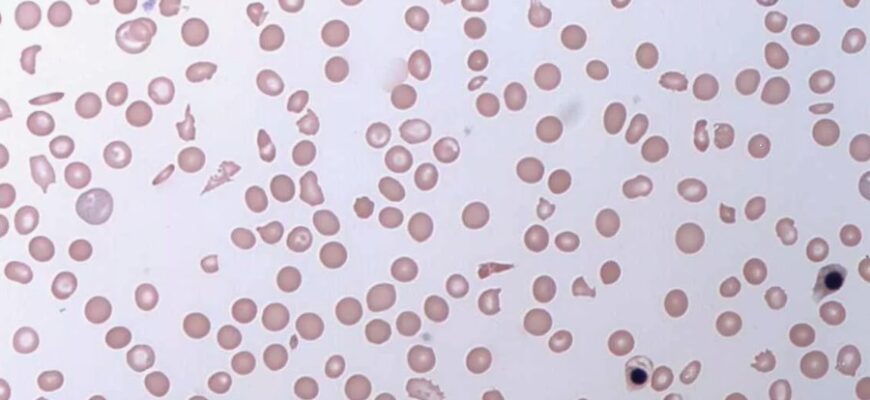
Апластична анемія: причини, симптоми та методи лікування захворювання

HEALTH
Що таке епідерміс Епідерміс — це поверхневий шар шкіри, той, що на самому “фасаді” нашого тіла. Але не поспішайте думати, що він простий чи незначний.
Що таке парацетамол. Його сутність. Що таке парацетамол? Це одне з найпоширеніших ліків у світі. Його без зайвих роздумів п’ють і при температурі
Що таке засоби гігієни: огляд, історія і значення Що таке засоби гігієни? Це питання не нове. Але чи знаємо ми всю правду? Чесно, навіть не усі замислюються над цим.
Що таке капа на зуби? Капа на зуби — такий непомітний порятунок для тих, хто страждає від потайки напруженого зубного апарату. Розберемось, що це таке?
Що таке апластична анемія? Апластична анемія — звучить ніби з моторошних історій про хвороби, яких ніхто не хоче. Але насправді це не тільки історії, це
Що таке емоції людини і як вони впливають на наше життя? Емоції — це ті загадкові почуття, які тріпотять у нашій душі, впливаючи на те, як ми бачимо світ
Що таке чакри людини: містичний погляд на енергію Чакри… Що це за дивні енергетичні центри, оселилися десь між реальністю та містикою?
Що таке жива вакцина? Жива вакцина — це справжнє диво біотехнології, яке використовує живі, але ослаблені мікроорганізми, щоб захистити нас від інфекцій.
Що таке білірубін? Білірубін — такий собі цікавий елемент. Він може здатися дрібницею, але насправді це важливий пігмент, що формується в нашому організмі.
Що таке ібупрофен? Ібупрофен, чув про таке? Напевно, так. Якщо ні — час дізнатися. Ібупрофен — це ненаркотичний анальгетик, який допомагає зняти біль